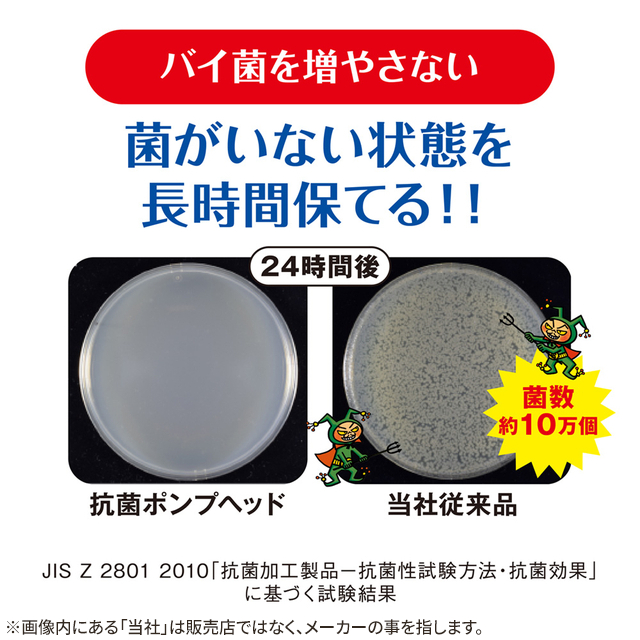

[3種類から1セット選択] キレイキレイ 薬用 泡 ハンドソープ つめかえ用特大サイズ 800mL×4個 医薬部外品 ライオン
(5件)
Pontaパス特典
サンキュー配送
2,750円(税込)
0ポイント(1%)
補足事項
一度に39個まで購入可能
販売期間:2023/04/14 10:00〜
ロットナンバー
561800883
商品説明
 ※同じ種類を4個お届けします。3種類から1セットお選びください。
※同じ種類を4個お届けします。3種類から1セットお選びください。殺菌+消毒
きちんと殺菌し、バイ菌から手肌を守る
薬用
殺菌+消毒 きちんと殺菌し、バイ菌から手肌を守る 売上No.1(※1)のキレイキレイ薬用泡ハンドソープ
・殺菌成分が手にとどまる、殺菌ベール処方。
・ウイルス・細菌を除去(エンベロープ型ウイルスにてテスト。全てのウイルス・細菌に効果があるわけではありません)。
・菌を増やさない抗菌ボトル・ポンプヘッド採用。(抗菌ボトル・ポンプヘッドは全ての菌に有効ではありません。清潔に保ってください。)
・つめかえ用特大サイズ。
※1 2022年1月〜12月シリーズ累計販売金額インテージSRIハンドソープ市場
〈3種展開〉
・手に香りが残りにくいシトラスフルーティの香り
・清潔感のあるフローラルソープの香り
・もぎたてフルーツミックスの香り
※パッケージデザインのリニューアルに伴い、お届け時に旧パッケージと新パッケージが混在している可能性がございます。ご容赦いただけますようお願い申し上げます。
※リニューアルに伴い、一部成分に変更がございます。

- 商品詳細
商品名 キレイキレイ 薬用 泡 ハンドソープ つめかえ用特大サイズ 800mL×4個 医薬部外品 ブランド キレイキレイ メーカー ライオン 香り シトラスフルーティ、フローラルソープ、フルーツミックス 容量 800mL×4個 成分 【シトラスフルーティ】
有効成分:イソプロピルメチルフェノール
その他の成分:PG、ヤシ油脂肪酸アシルグリシンK液、ラウリン酸、モノエタノールアミン、水酸化K、ミリスチン酸、パルミチン酸、リン酸1K、香料、ポリオキシエチレントリデシルエーテル、EDTA、塩化ジメチルジアリルアンモニウム・アクリルアミド共重合体、赤106
【フローラルソープ】
有効成分:イソプロピルメチルフェノール
その他の成分:PG、ヤシ油脂肪酸アシルグリシンK液、ラウリン酸、モノエタノールアミン、水酸化K、ミリスチン酸、パルミチン酸、リン酸1K、香料、ポリオキシエチレントリデシルエーテル、EDTA、塩化ジメチルジアリルアンモニウム・アクリルアミド共重合体、赤106
【フルーツミックス】
有効成分:イソプロピルメチルフェノール
その他の成分:PG、ヤシ油脂肪酸アシルグリシンK液、ラウリン酸、モノエタノールアミン、水酸化K、ミリスチン酸、パルミチン酸、リン酸1K、香料、ポリオキシエチレントリデシルエーテル、EDTA、塩化ジメチルジアリルアンモニウム・アクリルアミド共重合体、黄4、赤106生産国 日本 ※ こちらの商品は国内正規品となります。 使用方法 手に広げて洗い、その後よくすすいでください。 販売名 シトラスフルーティ:キレイキレイ薬用泡ハンドソープNa
フローラルソープ:キレイキレイ薬用泡ハンドソープNb
フルーツミックス:キレイキレイ薬用泡ハンドソープNcJANコード 4904740527987
4904740527994
4904740528007区分 医薬部外品
注意事項
・湿疹、皮ふ炎(かぶれ、ただれ)等の皮ふ障害があるときには、悪化させるおそれがあるので使わないでください。
・使用中、かぶれたり、刺激等の異常を感じたときには使用を中止し、商品を持参し医師に相談してください。
・目に入ったときは、すぐに洗い流してください。
・乳幼児や認知症の方の誤飲等を防ぐため、置き場所に注意してください。
・環境に配慮した薄型容器を使用しているので、持ち運びや保管時の破損に注意してください。
・お使いのモニターや端末により色の見え方が実際の商品と異なることがございますが、イメージ違いによる返品・交換は承ることができません。
・ご使用前に必ず、お届けした商品のラベルや注意書きをご確認ください。
・商品の改訂などにより、商品パッケージの記載内容と異なる場合があります。
・販売する商品は「つめかえ用」です。「本体」の画像は参考画像となります。
注記事項

レビュー
商品の評価:



 4.6点(5件)
4.6点(5件)
- お気に入り
- ハンドソープはコレが1番のお気に入りです。無くなる前に又、注文させて頂きます。
- まとめ買い
- 初めてまとめ買いしました助かりますすぐなくなるので丁度まとめ買いのがあり助かりましたありがとうございます。
- 重いので助かります。
- 洗剤と同梱してお願いしました。重いので玄関まで届けてもらえると助かります。又、見つけてお願いするつもりです。
- きめ細かい泡
- 泡がきめ細かく、すすぎも早く、香りも残りすぎず、気に入っています。
- 配送は
- 早かったです。 お値段がもう少し安くなれば嬉しいです。
すべて見る
お店の情報
お店の評価:



 -点(0件)
-点(0件)
連絡・応対
-
配送スピード
-
梱包
-













